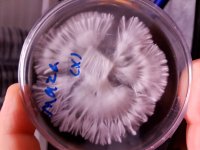
20190110_220349.jpg
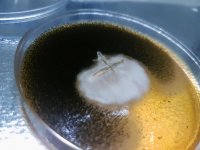
20190213_194722.jpg
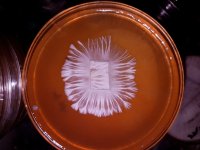
20190511_132050.jpg

i got into mycology when i was 16
now at 19 am finally taking it to the next level
here i will share experiments that have been successful

agar medium: 22g ground oats + 15 malt extract + 5g gypsum + 2g ground charcoal/carbon + 2g yeast for 1L final medium (also known as psilocybia's black agar)
bring 2L of tap water (pH at 7) to a boil, add the materials mentioned above ^, boil on medium heat for 30minutes, pass through metal strainer, move solution back to pot, add 30g agar powder and stirr, move to autoclav glass and autoclav at 15psi for 30-45 minutes and pour into dishes in front of your flow hood/ still air box
now at 19 am finally taking it to the next level
here i will share experiments that have been successful
agar medium: 22g ground oats + 15 malt extract + 5g gypsum + 2g ground charcoal/carbon + 2g yeast for 1L final medium (also known as psilocybia's black agar)
bring 2L of tap water (pH at 7) to a boil, add the materials mentioned above ^, boil on medium heat for 30minutes, pass through metal strainer, move solution back to pot, add 30g agar powder and stirr, move to autoclav glass and autoclav at 15psi for 30-45 minutes and pour into dishes in front of your flow hood/ still air box

amazing
amazing

:d
:d 






